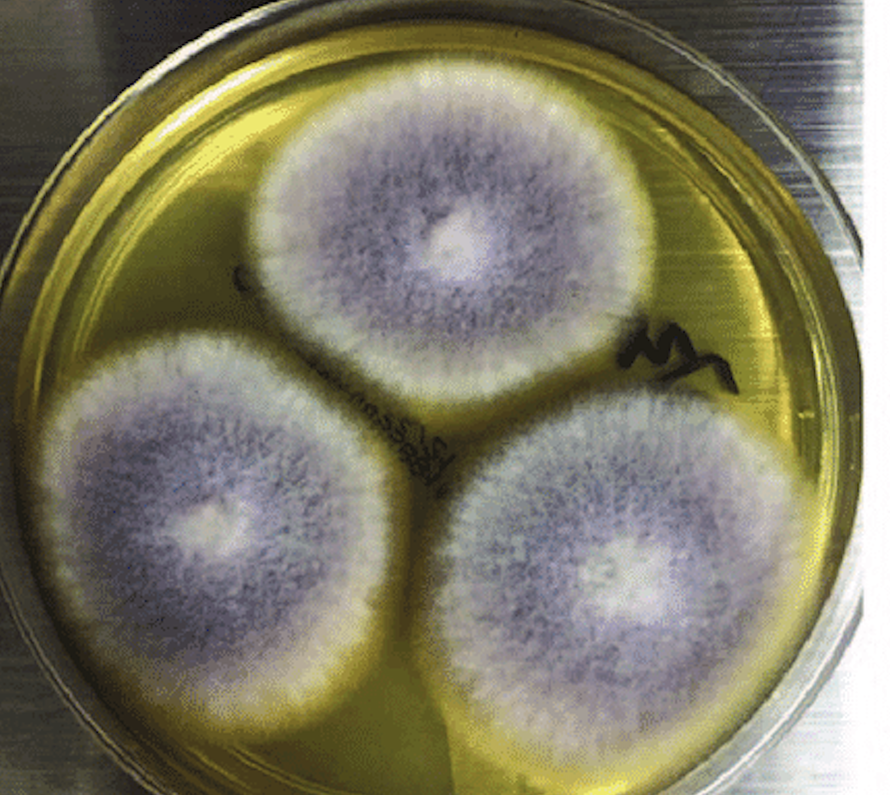

– Microorganismo causó la muerte de una persona en México y tiene a otras 24 internadas. Expertos de la Universidad de Talca indican que el aumento de casos podría estar asociado a la resistencia a los antimicrobianos, que la OMS declaró como una de las 10 amenazas mundiales contra la salud pública.
Las autoridades mexicanas de salud informaron recientemente el fallecimiento de una paciente a causa de una infección al sistema nervioso central provocada por el hongo Fusarium Solani, un microorganismo filamentoso que se encuentra “ampliamente distribuido en la naturaleza”, según explicó el director del Magíster en Ciencias Biomédicas de la Universidad de Talca, Sergio Wehinger.
El académico quien es integrante de la Facultad de Ciencias de la Salud de esa Institución detalló que, este patógeno es más conocido por causar enfermedades en muchas plantas, “y puede producir ciertas infecciones cutáneas y en las uñas -onicomicosis- sin revertir gravedad”.
Sin embargo, agregó que, para las personas inmunodeprimidas, como por ejemplo aquellas que padecen cáncer, leucemia, problemas graves al sistema inmunitario o debilitadas por la edad, pueden verse afectadas por este hongo de forma más severa. “El caso de la paciente fallecida en México se explica porque el hongo pasó a la sangre y de ahí al sistema nervioso central, y cualquier hongo que llegue a este sistema va a producir algo semejante a la meningitis causada por bacterias”, planteó.
Hay varios problemas con casos como este, señaló Wehinger: “La mayoría de este tipo de infecciones son causadas por bacterias que están desarrollando resistencia a los antimicrobianos, y por tanto son muy difíciles de tratar”.
El académico agregó que el año pasado hubo un caso similar en ese mismo país, con 70 personas afectadas por meningitis causada por este mismo patógeno, por lo que “claramente estamos viendo un hongo que se ha puesto más virulento frente al ser humano. Aparentemente contaminó material quirúrgico, lo que significa que es capaz de sobrevivir en condiciones hospitalarias, lo que siempre es una mala noticia”.
Causa multifactorial
Para Wehinger, se trata de un caso multifactorial, donde pudieron combinarse la resistencia a los antimicrobianos o aparición de cepas resistentes y hasta el calentamiento global, entre otros.
“Si bien el Fusarium no es un hongo peligroso para el ser humano, la resistencia a los antimicóticos puede tener algo que ver y comenzaremos a verlo más seguido causando enfermedades severas. Los microorganismos como los hongos pueden crecer favorecidos por el calentamiento global, que es otro factor en contra de la salud, lo que significa que tarde o temprano nos vamos a topar con alguno que nos cause problemas”, sostuvo.
De acuerdo al especialista, este caso es preocupante ya que se observó un hongo que se adhirió al material quirúrgico, resistiendo los protocolos de limpieza que se efectúan habitualmente en un centro hospitalario.
Resistencia antifúngica
Uno de los aspectos principales que se analizan en casos como este, es el tema de la resistencia a los antibióticos y antimicóticos, que ha advertido la Organización Mundial de la Salud.
Esteban Durán, académico de la Facultad de Ciencias de la Salud de la misma Casa de Estudios, explicó que, efectivamente la resistencia antifúngica está en crecimiento, a pesar de que se han desarrollado nuevos fármacos.
“Por este escenario es que el tratamiento de pacientes con infecciones fúngicas invasoras es cada vez más complicado. Muchos casos terminan en un fallo terapéutico y posterior muerte del paciente”, explicó.
Tal como señaló Wehinger, Durán recalcó que sobre el 90% de pacientes con enfermedades causadas por hongos, tienen una preexistencia (inmunodeprimidos, diabetes, edad avanzada, quemaduras de gran extensión, etc.)
“Los principales hongos microscópicos toxigénicos son el aspergillus, penicillium, fusarium y la alternaria, que están con frecuencia ligados a este tipo de infecciones. Por otra parte, puede haber una toxicidad crónica o aguda. Esta última provoca rápidamente la muerte, mientras que la crónica es cuando se van acumulando micotoxinas en el tiempo en nuestro cuerpo y provocan una enfermedad después de muchos años”, finalizó.